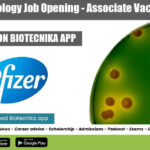
Pfizer Microbiology Job Opening
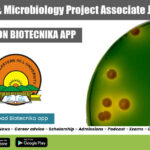
NEHU Project Associate Job

Home Search
biology - search results
If you're not happy with the results, please do another search
Biotecnika Times Newsletter 19.04.2022 IISc MSc / PhD Job, BIS Jobs, PGT Biology, IISER...
Biotecnika Times - IISc MSc / PhD Job, BIS Jobs, PGT Biology, IISER PhD
Bureau of Indian Standards (BIS) Recruitment 2022, Online Applications Invited
BIS Jobs...
PGT Biology Recruitment 2022 at Sainik School, Applications Invited
PGT Biology Recruitment 2022 at Sainik School, Applications Invited
PGT Biology Recruitment 2022 at Sainik School, Applications Invited. Sainik School Mizoram PGT Biology 2022 job...
Telscie Genetics Recruitment 2022 – Biotech, Biochem & Microbiology
Telscie Genetics Project Jobs For Biochem, Biotech & Microbiology
Telscie Genetics Project Jobs For Biochem, Biotech & Microbiology. Project Fellow (Biochemistry & Microbiology) vacancies are...
IISc Principal Project Associate & Project Associate Jobs In Dept. of Microbiology & Cell...
IISc Project Jobs 2022 In Dept. of Microbiology & Cell Biology
IISc Project Jobs 2022 In Dept. of Microbiology & Cell Biology. MSc and PhD...
Pfizer Microbiology Job Opening – Associate Vacancy Available
Pfizer Microbiology Job Opening - Associate Vacancy Available
Pfizer Microbiology Job Opening - Associate Vacancy Available. Pfizer is hiring candidates for an Associate -Microbiology vacancy....
IISER Pune PhD Admissions 2022 (August) – Biology PhD Programme
IISER Pune PhD 2022 Admissions (August) - Biology PhD Programme
IISER Pune PhD 2022 Admissions (August) - Biology PhD Programme. IISER Pune Admissions for PhD...
ICMR-NIMR JRF Job For Biotech, Biochem, Microbiology & Mol Bio
ICMR-NIMR JRF Job For Biotech, Biochem, Microbiology & Mol Bio
ICMR-NIMR JRF Job For Biotech, Biochem, Microbiology & Mol Bio. MSc biotech, biochem, microbiology and...
ICRISAT JRF Job For Biotech & Biology, Online Application Process
ICRISAT JRF Job For Biotech & Biology, Online Application Process
ICRISAT JRF Job For Biotech & Biology, Online Application Process. MSc Biology, Biotechnology Junior Research...
VIT Vellore Research Associate Job Opening For Bioinformatics & Computational Biology
VIT Vellore RA Job Opening For Bioinformatics & Comp Biology
VIT Vellore RA Job Opening For Bioinformatics & Comp Biology. PhD Bioinformatics, Computational Biology RAIII...
CSIR-IICB Project Associate Job Opening For Biotech, Biochem & Microbiology
IICB Job Opening 2022 - Biotech, Biochem & Microbiology Vacancy
IICB Job Opening 2022 - Biotech, Biochem & Microbiology Vacancy. MSc Biotech, Microbiology or Biochemistry....
PGIMER Preparing for Viral Pandemics Project Recruitment For Biotech, Microbiology
PGIMER Bioinformatics Job - Biotech, Mol Bio, Microbiology Apply
PGIMER Bioinformatics Job - Biotech, Mol Bio, Microbiology Apply. MSc & PhD Non-Medical Research Scientist Job....
NEHU Biotech & Microbiology Project Associate Job Available
NEHU Project Associate Job For Biotech & Microbiology
NEHU Project Associate Job For Biotech & Microbiology. MSc Biotechnology/ Microbiology candidates are invited to apply for...
How To Score Full Marks In NEET Biology? Top 10 Strategies Discussed
How To Score Full Marks In NEET Biology - 10 Golden Rules To Score 100% Marks In Biology In NEET Exam.
Let's start with some...
CSIR-IICB Biotech, Biochem, Genetics & Microbiology JRF Vacancy Available
IICB Job Latest For Biotech, Biochem, Genetics & Microbiology
IICB Job Latest For Biotech, Biochem, Genetics & Microbiology. MSc Biotech, Genetics, Microbiology or Biochemistry. jobs...
Earn Rs. 50,000 pm as Technician at THSTI – Life Sciences, Biotech & Microbiology...
THSTI Lab Tech Vacancy For Life Sciences, Biotech & Microbiology
THSTI Lab Tech Vacancy For Life Sciences, Biotech & Microbiology. Life Sciences/ /Microbiology/Biotechnology senior technician...